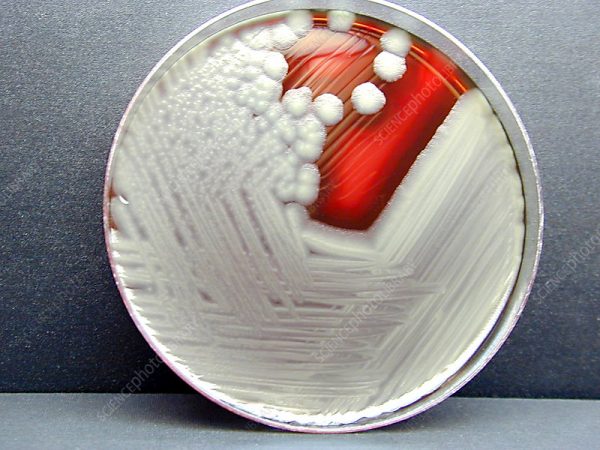
توکسین بایندر | خوراک دام | خوراک طیور |

باسیلوس سرئوس یک باکتری تشکیل دهنده اسپور است که باعث تولید سموم می شود که باعث استفراغ و اسهال می شود علائم معمولاً خفیف و کوتاه مدت (تا 24 ساعت) است. B. cereus معمولاً در محیط (مانند خاک) و همچنین انواع غذاها یافت می شود. اسپورها قادرند در محیط های خشن از جمله درجه حرارت طبیعی زنده بمانند. باسیلوس سرئوس یک گرم مثبت، حرکتی (تاژک دار)، اسپور شکل دهنده، باکتری شکل دار است که متعلق به جنس باسیلوس است. باسیلوس در طبیعت گسترده است و به راحتی در خاک یافت می شود. به دلیل متابولیسم، اسپورها به استرس محیطی مقاوم تر از سلول های رویشی می باشند گونه های جدا شده از مواد غذایی و انسان را می توان به عنوان سویه های مزوفیل یا سایکروفیل تقسیم کرد. سویه مزوفیل در دمای 37 درجه سانتی گراد خوب رشد می کنند اما کمتر از 10 درجه سانتیگراد رشد نمی کنند. سویه های سایکروفیل به خوبی در دمای یخچال رشد می کنند اما در دمای 37 درجه سانتی گراد ضعیف رشد می کنند.
Bacillus cereus ATCC9634
Bacillus cereus ATCC11778

دیدگاهها
هیچ دیدگاهی برای این محصول نوشته نشده است.